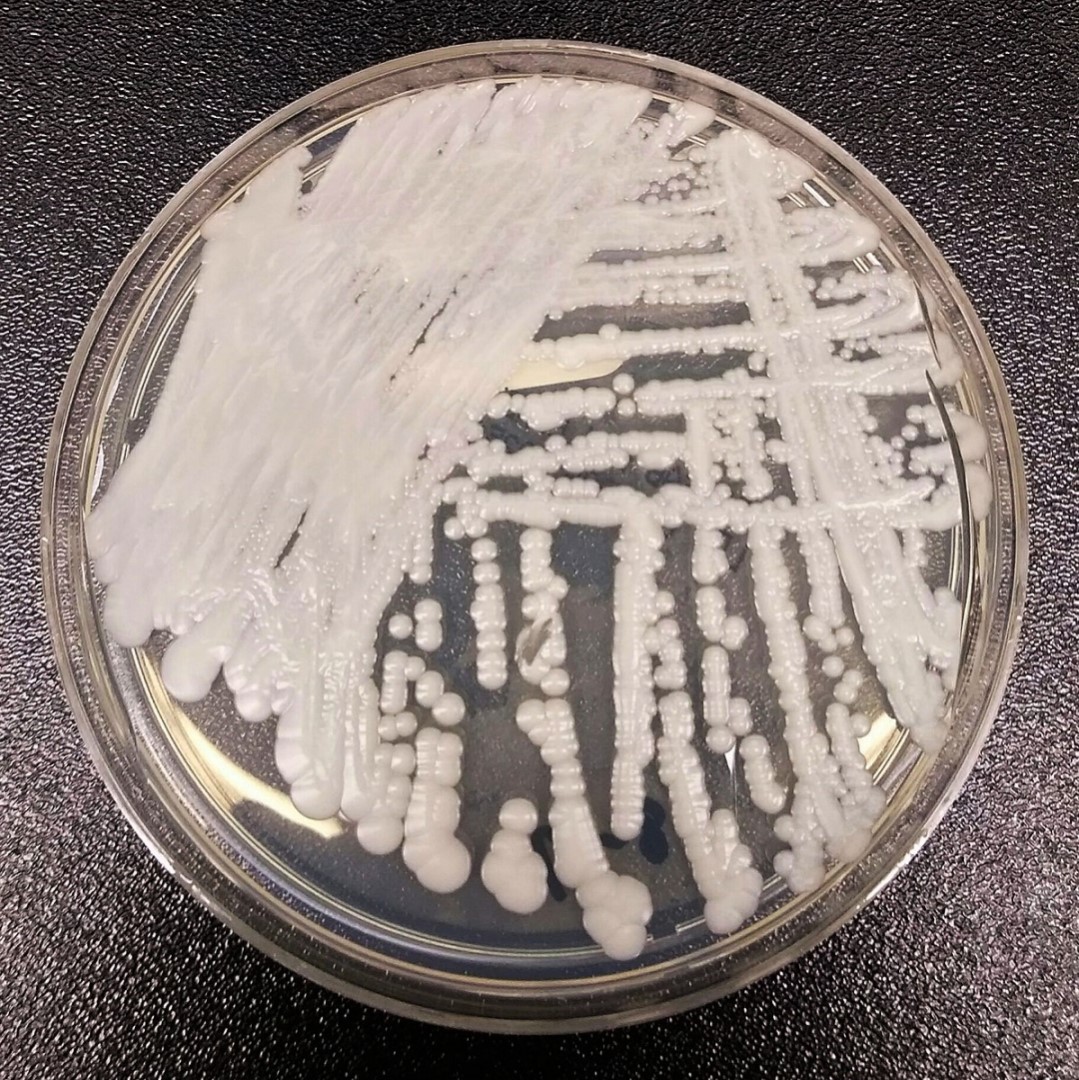

First case of Candida auris reported in Washington with local transmission suspected
On Jul. 19, 2023, the King County Department of Health issued a Health Advisory that Candida auris (C. auris) had been identified in a patient in Washington. C. auris is an emerging often multidrug-resistant fungal pathogen that has caused outbreaks that are difficult to control in healthcare facilities outside of Washington.
C. auris was first reported in 2009 outside of the U.S. and has since emerged globally as a life-threatening, highly transmissible, often multidrug resistant yeast that has caused difficult to control healthcare outbreaks. Invasive infections with any Candida species can be fatal. Based on information from a limited number of patients, more than 1 in 3 people with C. auris infections have died. Patients needing long term acute care and indwelling devices are at the highest risk for acquisition. International healthcare is often the initial source of introduction of C. auris to a region and subsequent healthcare transmission may occur due to lapses in infection control practices.
C. auris can be misidentified as a number of different organisms when using traditional phenotypic methods for yeast identification such as VITEK 2 YST, API 20C, BD Phoenix yeast, and Microscan. An increase in infections due to unidentified Candida species in a patient care unit, including increases in isolation of Candida from urine specimens, should also prompt suspicion for C. auris.
Tags:
Source: King County, WA
Credit:
